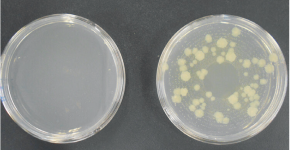
細菌の増殖を示した写真

コンビニごはんでもバランスの良い食事をとろう
中高校生の皆さんの中には、お昼ごはんや塾の前の夕ごはんなどをコンビニエンスストアで購入することが多い人もいるのではないでしょうか。その際に、栄養面を気にしたことがありますか?まずは、皆さんの食品の選び方についてチェックしてみましょう。

城南区シンボルキャラクター「ニッコりん」
コンビニごはん、こんな選び方をしていませんか?
選びがちな食事の例と、その栄養バランス(注)、問題点をみてみましょう。
(注)グラフの三角形は、たんぱく質、脂質、炭水化物のバランスを示しています。ピンクの三角形は食事例を示しており、ピンクの三角形が、グレーで二重に描かれている三角形内で、できるだけ正三角形に近い形で収まるのが理想的な栄養バランスになります。
| A:牛丼のみ | B:菓子パンとジュースのみ | |
|---|---|---|
| 栄養バランス |  |
 |
| 問題点 | 脂質が多い 野菜が少ない |
たんぱく質が少ない 野菜がない 砂糖が多い |
| C:パスタ(カルボナーラ)のみ | D:サンドイッチとコーヒーのみ | |
|---|---|---|
| 栄養バランス |  |
 |
| 問題点 | 野菜がない 脂質が多い |
野菜がない 炭水化物も少ない |
| E:おにぎりとお茶のみ | F:サラダのみ | |
|---|---|---|
| 栄養バランス |  |
 |
| 問題点 | たんぱく質のものがない 野菜がない 炭水化物の量も足りない |
炭水化物が少ない たんぱく質が少ない ドレッシングの油が多い |
このように「単品派」の食事は、栄養のバランス(たんぱく質、脂質、炭水化物)が崩れてしまいます。
また、D・E・Fの3つの例は、栄養バランスに加えてカロリーも低すぎるため、成長期の皆さんには量的にも不足しています。
コンビニごはん、オススメの選び方の基本
栄養バランスを良くするには、どのような選び方をしたらいいでしょうか?
答えは、これまで皆さんが食べてきた給食と同じように「主食・主菜・副菜をそろえる」ことです。

主食
米、パン、めん類などの穀類を主材料とする料理で、主として炭水化物、エネルギーの供給源



主菜
魚や肉、卵、大豆製品などを使った副食の中心となる料理で、主としてたんぱく質の供給源


副菜
野菜などを使った料理で、主食と主菜に不足するビタミン、ミネラル、食物繊維などを補う重要な役割



コンビニごはん「単品派」の栄養バランスアップ実践編
では、「単品派」の食事例を一部用いて、栄養バランスをアップしてみましょう。ポイントは、プラス+の発想です!
「牛丼」にプラス

牛丼は「主食」と「主菜」が組み合わさったメニュー。そこに「副菜」となるサラダや酢の物をプラス+!
「おにぎりとお茶」にプラス

おにぎり1個では炭水化物も少ないため、「主食」としておにぎりを追加、「主菜」としてから揚げ、「副菜」としてサラダや野菜たっぷりの汁物をプラス+!
「サンドイッチ」にプラス

サンドイッチは「主食」(パン)と「主菜」(卵やツナ、ハム、チーズ等)の組み合わせだったら、そこに「副菜」としてミネストローネやサラダをプラス+!
さらにヨーグルトなどの「乳製品」や「果物」を足すとgood!
「パスタ」にプラス

パスタは「主食」(麺)ですが、具が「主菜」(肉や魚介)がメインのものだったら、そこに「副菜」としてサラダ、さらに牛乳をプラス+!
栄養バランスを整えるコツ1
サンドイッチの場合はできるだけ野菜の入ったミックスサンドを、パスタの場合は野菜とたんぱく源(肉・魚・卵など)の両方入ったものを選びましょう。
栄養バランスを整えるコツ2
成長期の皆さんは特に、不足しがちなカルシウムを補う牛乳やヨーグルトをプラスすること、また、主食がサンドイッチのように少し軽めの場合には、糖質やビタミンC、食物繊維も豊富なバナナをプラスすることをオススメします。
栄養バランスで選ぶなら幕の内弁当がおススメ!
幕の内弁当は、「主食・主菜・副菜」がそろっているので理想的です。
選ぶポイント
・彩り豊かで野菜が多い弁当を選ぶ
・食材の種類が多いお弁当を選ぶ
・野菜が少なめなら野菜ジュースを添えると良い(野菜ジュースは、あくまでも野菜摂取の補助として利用しよう!)


飲みかけのペットボトル、長時間置いていませんか? 食品衛生メモ
コンビニではお弁当などとあわせて購入するペットボトル飲料。持ち歩きに便利ですが、飲みかけの状態で長時間置く場合は注意が必要です。
常温で置いておくと細菌だらけに
直接口をつけて飲むと、唾液の中のさまざまな細菌がボトルの中に入ります。そのまま放置すると、細菌が繁殖すると言われています。
次の写真は細菌検査の一例です。写真の左側は4℃、右側は30℃で保管したときの細菌の様子です。
口をつけたペットボトルの麦茶を使って、細菌が時間が経つにつれどれだけ増えるか実験したところ、次のグラフのようになりました。30℃でたくさん増えているように、気温が高い夏は、細菌も増えやすいため、より一層注意が必要です。

衛生的に飲む方法
1直接口をつけず、コップに注いで飲む
2飲みかけは冷蔵庫に入れ、早く飲み切る
3短時間で飲み切れる小さいサイズを選ぶ
このほか、魔法瓶など保冷できる水筒を使えば、細菌が増えるスピードを抑えることができます。
「口をつけて何時間までは大丈夫」と明確なものはありませんが、衛生的な飲み方を心掛けて、おいしく水分補給しましょう。

飲みかけのペットボトルは大丈夫? 「暮らし上手のヒントVol.6」






